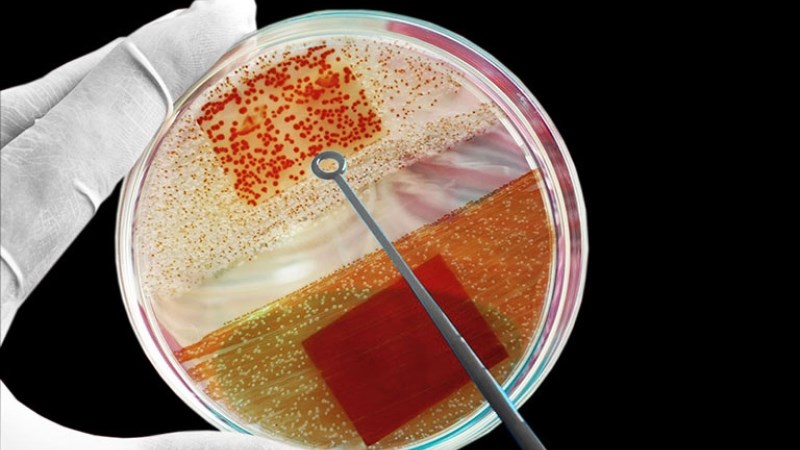
Nuôi cấy phân lập vi khuẩn giúp bác sĩ chẩn đoán hạ cam mềm

Hạ cam mềm là một bệnh không phổ biến nhưng những người quan hệ tình dục không an toàn rất dễ mắc phải. Bệnh có thể dẫn đến sưng, đau bẹn hoặc thậm chí bội nhiễm nếu không được điều trị đúng cách. Cùng tìm hiểu trong bài viết dưới đây để biết hạ cam mềm là gì, nguyên nhân, dấu hiệu và cách chữa trị hiệu quả nhé!
1Bệnh hạ cam mềm là gì?
Hạ cam mềm là bệnh lý lây truyền qua đường tình dục do vi khuẩn Haemophilus ducreyi gây ra. Vi khuẩn này tấn công các mô ở cơ quan sinh dục và gây nên những vết loét tại đây. Đây là bệnh lý thường gặp ở cả nam và nữ độ tuổi quan hệ tình dục.[1]
-800x450.jpg)
Hạ cam mềm do vi khuẩn Haemophilus ducreyi gây ra
2Nguyên nhân
Bệnh hạ cam mềm rất dễ lây qua đường tình dục. Nguyên nhân là do vi khuẩn Haemophilus ducreyi xâm nhập vào cơ thể qua các vết xước trên da khi quan hệ tình dục.
Bệnh hạ cam mềm được lây truyền qua 2 con đường:
- Quan hệ tình dục không an toàn: Bệnh hạ cam mềm chủ yếu lây truyền qua đường tình dục, bao gồm quan hệ tình dục không an toàn với người có vết thương hở hoặc các vết loét hạ cam tiếp xúc trực tiếp giữa hai người với nhau.
- Tiếp xúc vật lý: Bệnh cũng có thể lây truyền thông qua tiếp xúc với vùng bị nhiễm bệnh từ người này sang người khác, chẳng hạn như qua các vết thương mở hoặc tổn thương trên da.[2]
3Dấu hiệu
Bệnh hạ cam mềm có thể làm xuất hiện những dấu hiệu sau:
- Ban đầu xuất hiện sẩn mềm có viền đỏ xung quanh, sau 2 - 4 ngày chuyển thành mụn mủ. Sau vài ngày đến 2 tuần, mụn vỡ và hình thành loét, mềm, đau, có bờ rõ. Bề mặt loét màu vàng hoặc xám, phù nề, dễ chảy máu.
- Có thể có một hoặc nhiều vết loét, hình thành mảng rắn.
- Nam giới thường bị ở bao quy đầu, rãnh quy đầu, thân dương vật. Phụ nữ có thể xuất hiện ở âm đạo, hậu môn, niêm mạc miệng và các vị trí ngoài khu vực sinh dục.
- Có hạch ở bẹn gây sưng nóng đỏ đau, hóa mủ sau 1 - 2 tuần, thường xuất hiện ở nam giới.
- Sốt nhẹ và mệt mỏi.
- Phụ nữ có thể thấy đau khi đi tiểu, khi đi ngoài có thể chảy máu trực tràng, đau khi quan hệ hoặc có khí hư.
- Ở bệnh nhân HIV/AIDS, vết loét lớn hơn, lâu lành và ít gây viêm hạch bạch huyết so với người khác.[2]

Các vết loét có viền đỏ xung quanh ở người bệnh hạ cam mềm
4Biến chứng nguy hiểm
Bệnh hạ cam mềm (chancroid) có thể gây ra một số biến chứng nếu không được điều trị kịp thời hoặc điều trị không đúng cách. Các biến chứng của bệnh hạ cam mềm bao gồm:
- Nhiễm trùng lan rộng: Nếu không được điều trị, vi khuẩn Haemophilus ducreyi có thể lan rộng ra các vùng khác trong cơ thể, gây ra nhiễm trùng huyết (sepsis) hoặc nhiễm trùng trong các cơ quan khác như khớp và gan.
- Sưng chảy mủ: Các loét bị nhiễm vi khuẩn có thể phát triển thành những sưng chảy mủ lây truyền nhiễm trùng sang người khác.
- Sẹo và vết thương: Việc tự điều trị hoặc để bệnh kéo dài có thể dẫn đến việc hình thành sẹo và vết thương ở vùng bị nhiễm.
- Tăng nguy cơ lây nhiễm HIV: Những người bị nhiễm bệnh hạ cam mềm có thể dễ dàng bị nhiễm HIV qua đường tình dục nếu có quan hệ tình dục không an toàn với người mang virus HIV.
5Cách chẩn đoán
Để chẩn đoán bệnh hạ cam mềm (chancroid), bác sĩ thường sẽ sử dụng một số phương pháp kiểm tra và quan sát các triệu chứng của bệnh. Các phương pháp chẩn đoán bao gồm:
- Hỏi bệnh sử: Bác sĩ sẽ tiến hành thăm hỏi bệnh nhân nhằm phát hiện những dấu hiệu trên cơ thể người bệnh liệu có liên quan tới bệnh hạ cam mềm hay không.
- Nuôi cấy xác định vi khuẩn hoặc phân lập PCR: Khi nghi ngờ người bệnh đã bị nhiễm hạ cam mềm, bác sĩ sẽ lấy dịch chảy ra từ vết loét của người bệnh và gửi đến phòng thí nghiệm để tiến hành nuôi cấy xác định vi khuẩn hoặc phân lập PCR.[3]
Nuôi cấy phân lập vi khuẩn giúp bác sĩ chẩn đoán hạ cam mềm
6Khi nào cần gặp bác sĩ
Các dấu hiệu cần gặp bác sĩ
Nếu bạn thấy xung quanh bộ phận sinh dục xuất hiện bất cứ vết loét nào gây đau đớn, sưng tấy, hãy đến gặp bác sĩ để được thăm khám và điều trị kịp thời.
Bên cạnh đó, khi được chẩn đoán mắc bệnh lây qua đường tình dục, hãy thông báo cho đối phương của bạn và cùng nhau đi khám để phát hiện và điều trị sớm nhất có thể.[2]
Nơi khám chữa hạ cam mềm
Nếu thấy các dấu hiệu bất thường, bạn nên đến các cơ sở y tế gần nhất, phòng khám chuyên khoa Da liễu hoặc các bệnh viện đa khoa tại địa phương để được thăm khám kịp thời.
Ngoài ra, có thể tham khảo một số bệnh viện lớn, uy tín dưới đây để được chẩn đoán và tư vấn điều trị phù hợp:
- Tp. Hồ Chí Minh: Bệnh viện Da Liễu Tp.HCM, Bệnh viện Đại học Y Dược, Bệnh viện Nhân dân 115.
- Hà Nội: Bệnh viện Da liễu Trung ương, Bệnh viện Bạch Mai, Bệnh viện Đại học Y Hà Nội.
7Các phương pháp chữa hạ cam mềm
Bạn có thể được chỉ định điều trị hạ cam mềm ngay lập tức mà không cần chờ kết quả xét nghiệm. Có các lựa chọn điều trị khuyến nghị như sau:
- Sử dụng Azithromycin 1g uống hoặc Ceftriaxone 250mg tiêm bắp chỉ một lần duy nhất.
- Sử dụng Erythromycin 500 mg uống 4 lần/ngày trong 7 ngày hoặc Ciprofloxacin 500 mg uống 2 lần/ngày trong 3 ngày.
Lưu ý, sử dụng thuốc phải được sự hướng dẫn và chỉ định của bác sĩ. Tránh tự ý sử dụng thuốc, nếu không sẽ dẫn đến các tác dụng phụ nguy hiểm không đáng có.
- Đối phương của người bệnh nên được khám và điều trị nếu họ có quan hệ tình dục với bệnh nhân trong 10 ngày trước khi các triệu chứng của bệnh nhân bắt đầu xuất hiện.
- Bệnh nhân bị săng cần phải xét nghiệm huyết thanh để tìm giang mai và HIV trong 3 tháng.[4]
8Biện pháp phòng ngừa
Cách tốt nhất để phòng ngừa bệnh hạ cam mềm là quan hệ tình dục an toàn với một số biện pháp như:
- Đeo bao cao su đúng cách.
- Quan hệ tình dục chung thủy.
- Thông báo cho đối phương nếu bạn được chẩn đoán mắc hạ cam mềm.
- Tuyệt đối không quan hệ tình dục trong thời gian điều trị.[5]
Bài viết trên đã chia sẻ về bệnh hạ cam mềm, dễ lây truyền và để lại nhiều biến chứng nguy hiểm. Do đó khi nhận thấy cơ thể xuất hiện nhiều triệu chứng giống với bệnh hạ cam mềm, bạn nên đi khám đến được bác sĩ chẩn đoán kịp thời. Hãy chia sẻ tới người thân, bạn bè nếu thấy bài viết hữu ích nhé!
Nguồn tham khảo
Xem thêm 